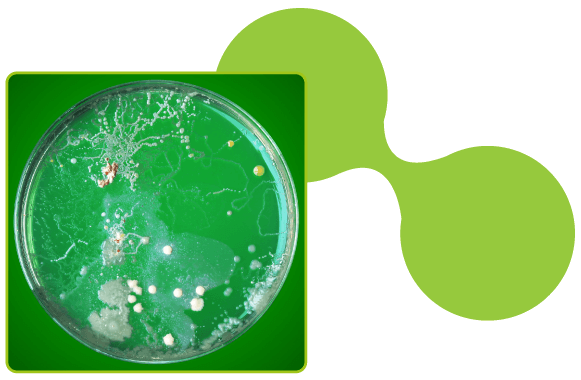

O poder germicida do ozônio é geralmente específico em relação a determinada espécie de microrganismo. A ação inicial do ozônio é no fungo, impedindo seu crescimento rapidamente principalmente se estiver no estágio inicial de ataque a superfície do produto. Depois, destrói as culturas formadas inclusive possui capacidade de neutralizar esporos.
O ozônio ataca imediatamente as células da superfície e tem poder de penetração que varia com cada tipo de alimento. A ozonização aplicada em carne refrigerada estocada destruiu os microrganismos superficiais, particularmente os da família Pseudomonas, responsáveis pela deterioração.
Aumentando-se o teor de umidade da câmara, eleva-se, favoravelmente, o efeito germicida do ozônio. Isto é conseguido pôr causar “cansaço” aos micróbios e torná-los mais susceptível à destruição. Testes realizados com carne mostraram que o ozônio é mais eficiente se a superfície tem uma umidade relativa de cerca de 60% (sessenta por cento).
Os vírus em geral são muito mais resistentes ao ozônio do que as bactérias vegetativas, porém menos resistentes que as bactérias esporuladas. Já os vírus na forma de fagos são bastante sensíveis ao ozônio. Os vírus patogênicos geralmente apresentam um tempo de permanência bem maior no ambiente do que as bactérias. O ozônio age sobre as proteínas que compõem o capsídeo viral, ocorrendo o comprometimento da capacidade infecciosa do vírus, uma vez que essas proteínas são responsáveis pela fixação do vírus na célula hospedeira. Altas concentrações de ozônio podem destruir completamente o capsídeo.
A ação sobre os protozoários e a resistência de microrganismos ao ozônio ou qualquer agente de desinfecção é influenciada pela espécie e pela forma que os mesmos aparecem no meio. Os cistos de protozoários são bem mais resistentes que a forma livre. Sabe-se também que os cistos de protozoários são mais resistentes do que as bactérias vegetativas e os vírus.